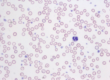

Begriffserklärung
Clinical Consensus Statements und Guidelines stellen von einem Expertenkomitee herausgegebene einheitliche Konsenserklärungen und Leitlinien in der Medizin dar.
Für wichtige und häufig auftretende Krankheitsbilder in der Veterinär- und Humanmedizin sind derartige Konsenserklärungen zu Pathophysiologie und klinische Leitlinien zu Diagnostik und Therapie verfügbar. Diese werden auf Grundlage evidenzbasierter Daten zusammengestellt und wenn nötig kommentiert. Ein Gremium von Expertinnen und Experten des jeweiligen Gebiets und Mitgliedern verschiedener Fachorganisationen erarbeitet einen Entwurf, welcher schließlich einem Journal vorgelegt wird und den Peer-Review-Prozess durchläuft. Nach Prüfung der Inhalte werden anschließend Konsenserklärungen oder klinische Leitlinien veröffentlicht. Für den Inhalt dieser Erklärungen sind die Autorinnen und Autoren verantwortlich.
Fachorganisationen
Konsenserklärungen und klinische Leitlinien werden in vielen Bereichen der Veterinärmedizin und von verschiedenen internationalen und nationalen Fachgesellschaften herausgegeben. In Tabelle 1 sind einige Organisationen im Bereich Kleintiermedizin zusammengestellt, die Konsenserklärungen herausgeben und/oder sammeln und auf ihren Webseiten veröffentlichen. Die Aufzählung ist dabei keineswegs vollständig, sondern fasst wichtige Herausgeber im Bereich Infektionserkrankungen beim Kleintier zusammen. Die meisten Konsenserklärungen sind online über „PubMed“ oder andere Suchmaschinen frei verfügbar (open access) und benötigen keinen lizensierten Bibliothekszugang.
Viele Konsenserklärungen werden von der ACVIM (American Journal of Veterinary Internal Medicine) erarbeitet. Sie befassen sich vorwiegend mit internistischen Erkrankungen in der Kleintier- und Pferdemedizin. Auf ihrer Webseite finden sich allerdings auch Beiträge zu Infektionserkrankungen bei Rindern. Die Konsenserklärungen werden im Journal of Veterinary Internal Medicine publiziert.
-
Abb. 1: Junges Meerschweinchen mit typischer krustiger Läsion auf dem Nasenrücken bei Dermatophytose
Bildquelle: Dr. J. Hein
-
Abb. 2: Probenentnahme für die Dermatophytenuntersuchung mittels McKenzie-Brush
Bildquelle: Dr. J. Hein
Tabelle 1: Beispiele für Fachorganisationen, die Konsenserklärungen erarbeiten
| Fachgesellschaft | Schwerpunkte | Vorwiegende Tierarten | |
| ACVIM | American College of Veterinary Internal Medicine | Innere Medizin | Kleintiere, Pferde |
| WSAVA | World Small Animal Veterinary Association | breit gefächert | Kleintiere |
| FECAVA | Federation of European Companion Animal Veterinary Associations | breit gefächert | Kleintiere |
| BSAVA | British Small Animal Veterinary Association | breit gefächert | Kleintiere |
| ISFM | International Society for Feline Medicine | Katzenmedizin | Katzen |
| ISCAID | International Society for Companion Animal Infectious Diseases | Infektionskrankheiten | Kleintiere |
| ESCCAP | European Scientific Counsel Companion Animal Parasites | Parasiten, Dermatophyten | Kleintiere, Pferde |
| BTK | Bundestierärztekammer | breit gefächert, Antibiotikaleitlinien | Kleintiere, Pferde, Nutztiere u. a. |
Die FECAVA (Federation of European Companion Animal Veterinary Associations) als übergeordnete europäische Organisation im Bereich Kleintiere pflegt auf ihrer Webseite eine Liste mit Consensus Statements und stellt Übersichtsposter für Tierärzte (Abbildung 1) zum Einsatz antimikrobieller Wirkstoffe bei häufigen Infektionserkrankungen und Informationsmaterial für Tierhalter zum Thema Infektionserkrankungen, Antibiotikatherapie und Hygiene zur Verfügung. Die Poster und Informationsmaterialien sind in deutscher Sprache bei LABOKLIN bestellbar.
Die BSAVA (British Small Animal Veterinary Association) hat in Zusammenarbeit mit der SAMSoc (Small Animal Medicine Society) ein Buch zum verantwortungsvollen Einsatz von Antibiotika in Kombination mit zwei Postern zur Diagnostik und empirischen Therapie bei häufigen Infektionskrankheiten veröffentlicht. „PROTECT ME“, der BSAVA/SAMSoc Guide to Responsible Use of Antibacterials, stellt ein ausführliches Nachschlagwerk zum Thema Antibiotika allgemein wie auch speziell zu vielen Krankheitsbildern dar, mit denen man in der tierärztlichen Praxis häufig konfrontiert wird. So sind zum Beispiel Kapitel über bakterielle Augeninfektionen, gastrointestinale Infektionserkrankungen oder Harnwegsinfektionen enthalten.
Auf nationaler Ebene gibt in Deutschland die BTK (Bundestierärztekammer) viele Leitlinien zu einer großen Bandbreite des tierärztlichen Tätigkeitsfeldes heraus. Im Bereich Infektionsmedizin sollten hier die Antibiotikaleitlinien jedem bekannt sein.
Die Arbeitsgruppe Antimicrobial Working Group der ISCAID (International Society for Companion Animal Infectious Diseases) erarbeitet Konsenserklärungen und Leitlinien speziell für Infektionserkrankungen sowie deren Management und Behandlung bei Kleintieren. Im Folgenden sollen kurz die ISCAID-Konsenserklärungen für häufige infektiöse Erkrankungen bei Hunden und Katzen vorgestellt werden. Wie bei allen Leitlinien stellen sie Empfehlungen dar, die unter Gesichtspunkten der guten veterinärmedizinischen Praxis erarbeitet wurden und viele Fälle aus der Praxis abdecken, aber nie alle klinischen Erkrankungsbilder gleichermaßen vertreten können.
Leitlinien der ISCAID zum Management und zur Behandlung von Infektionskrankheiten
1. Umgang mit antimikrobiellen Wirkstoffen – Antibiotic Stewardship
Vor dem Hintergrund von Antibiotikaresistenzen und multiresistenten Keimen wird der bewusste und sparsame Einsatz von Antibiotika umso wichtiger, um auch in Zukunft deren Wirksamkeit zu erhalten. Daher wurden Leitlinien zum Antibiotikaeinsatz in der Kleintierpraxis (Antibiotic Stewardship) definiert, um den Praktizierenden eine Hilfestellung zu bieten, dem Patienten einerseits durch eine erfolgreiche Therapie helfen zu können und andererseits die Entwicklung von Resistenzen zu vermeiden. Diese Leitlinien beinhalten Teilnahmebereitschaft, prophylaktische Maßnahmen wie Impfungen, die bewusste Auswahl und den Einsatz eines Antibiotikums, die Ausarbeitung von Behandlungsplänen und die Erarbeitung und Weitergabe von Wissen. Die Erstellung eines praxiseigenen Resistenzmonitorings kann ebenfalls Teil des Antibiotic Stewardship sein.
2. Infektionen des Urogenitaltrakts
Die aktuellen Leitlinien zum Thema Harnwegsinfektionen wurden 2019 veröffentlicht. Entgegen der vorherigen Leitlinien aus dem Jahr 2011 werden Infektionen des Urogenitaltrakts in sporadisch auftretende bakterielle Zystitiden, wiederkehrende bakterielle Zystitiden, Pyelonephritiden und bakterielle Prostatitiden eingeteilt. Zudem werden auch die Themen subklinische Bakteriurie, Harnkatheter, chirurgische Eingriffe am Urogenitaltrakt und medikamentöse Auflösung von Harnsteinen behandelt. Die häufigsten Zystitiserreger sind Escherichia coli (Abbildung 2), andere Enterobakterien wie Proteus mirabilis sowie koagulasepositive Staphylokokken wie Staphylococcus aureus und Staphylococcus pseudintermedius (Abbildung 2).
In den Leitlinien wird jedes Krankheitsbild klassifiziert, anschließend werden Empfehlungen zur Diagnostik und Therapie gegeben und nachfolgend werden Hinweise zur Nachbetreuung der Patienten beschrieben.
Sporadisch auftretende bakterielle Zystitiden kommen häufig beim Hund und seltener bei der Katze vor. In der tierärztlichen Praxis stellen sie oft eine Indikation zum Einsatz von Antibiotika dar.
In den neuen Leitlinien wird bei den meisten beschriebenen Krankheitsbildern eine kürzere Antibiotikatherapie empfohlen. Bei der sporadisch auftretenden Zystitis soll zunächst auf eine initiale Therapie mit Antibiotika verzichtet werden, es wird erst einmal die Behandlung mit Entzündungshemmern empfohlen und anschließend wird nach Ergebnis der kulturellen Untersuchung und bei anhaltender klinischer Symptomatik eine antimikrobielle Therapie für 3 bis 5 Tage gestartet. Amoxicillin und Trimethoprim/Sulfonamid werden dabei als Mittel der ersten Wahl genannt. Bei Pyelonephritis und bakterieller Prostatitis ist es wichtig, dem Labor die Entnahmelokalisation anzugeben, da hier andere Auswertekriterien als die für Harne angewendet werden sollen.
3. Atemwegsinfektionen
In der tierärztlichen Praxis werden Hunde und Katzen mit Atemwegsinfektionen sehr häufig vorgestellt. In den Leitlinien der ISCAID werden verschiedene Erkrankungen wie akute und chronische Infektionen der oberen Atemwege, bakterielle Bronchitis, Pneumonie und Pyothorax dargestellt. Zu jedem Erkrankungskomplex werden die auslösenden Erreger und geeignete Proben für die Diagnostik beschrieben sowie Behandlungsempfehlungen gegeben. Doxycyclin wird dabei bei vielen bakteriellen Erkrankungen der Atemwege bei Hunden und Katzen als Mittel der ersten Wahl genannt.
4. Dermatologie
Die Leitlinien für die oberflächliche Follikulitis und Pyodermie beim Hund stammen aus dem Jahr 2014 und sind aktuell in Überarbeitung. Leitlinien zu Dermatophyten und Malassezien sind ebenfalls verfügbar. Der Hauptkeim bei kaniner oberflächlicher Follikulitis und Pyodermie ist Staphylococcus pseudintermedius. Empfohlen wird vorrangig die lokale Therapie mit antiseptischen Präparaten. Als empirisches Antibiotikum der ersten Wahl für die systemische Therapie werden Clindamycin, Cephalosporine der 1. Generation wie Cefalexin, Amoxicillin-Clavulansäure und Trimethoprim/Sulfonamid empfohlen.
Anwendungsverbote bestimmter antimikrobieller Wirkstoffe bei Tieren
Im Februar 2023 trat auf europäischer Ebene eine neue Gesetzgebung (Durchführungsverordnung EU 2022/1255) in Kraft, die die Anwendung bestimmter antimikrobieller Wirkstoffe (Antibiotika und Virostatika) und Antiparasitika bei Tieren verbietet, da diese Wirkstoffe ausschließlich der Humanmedizin vorbehalten bleiben sollen. Unter anderem dürfen Wirkstoffe wie Ticarcillin, Piperacillin, Meropenem und Imipenem nicht mehr bei Tieren angewendet werden.
Zusammenfassung
Clinical Consensus Statements und Leitlinien können eine große Hilfe für den Tierarzt darstellen. Sie fassen einheitlich aktuelle Informationen und Expertenmeinungen zu Diagnostik und Therapie bei häufigen Erkrankungen in der Veterinärmedizin zusammen. Konsenserklärungen sind in der Regel online frei verfügbar. Zu den häufigsten Infektionskrankheiten bei Kleintieren sind Übersichtsposter zu diagnostischem Vorgehen und empirischer Therapie verfügbar.
Weiterführende Literatur
-
Frey E, Costin M, Granick J, Kornya M, Weese JS. 2022 AAFP/AAHA Antimicrobial Stewardship Guidelines. J Am Anim Hosp Assoc. 2022 Jul 1;58(4):1-5. doi: 10.5326/1547-3317-58.4.1.
-
Hillier, Andrew; Lloyd, David H.; Weese, J. Scott; Blondeau, Joseph M.; Boothe, Dawn; Breitschwerdt, Edward et al. (2014): Guidelines for the diagnosis and antimicrobial therapy of canine superficial bacterial folliculitis (Antimicrobial Guidelines Working Group of the International Society for Companion Animal Infectious Diseases). In: Vet. Dermatol. 2014. 25 (3), 163-e43. DOI: 10.1111/vde.12118.
-
Lappin, M. R.; Blondeau, J.; Boothe, D.; Breitschwerdt, E. B.; Guardabassi, L.; Lloyd, D. H. et al. (2017): Antimicrobial use Guidelines for Treatment of Respiratory Tract Disease in Dogs and Cats: Antimicrobial Guidelines Working Group of the International Society for Companion Animal Infectious Diseases. In: J. Vet. Intern. Med. 2017, 31 (2), S. 279–294. DOI: 10.1111/jvim.14627.
-
Morris DO, Loeffler A, Davis MF, Guardabassi L, Weese JS. Recommendations for approaches to meticillin-resistant staphylococcal infections of small animals: diagnosis, therapeutic considerations and preventative measures.: Clinical Consensus Guidelines of the World Association for Veterinary Dermatology. Vet Dermatol. 2017 Jun;28(3):304-e69. doi: 10.1111/vde.12444.
-
Weese JS, Giguère S, Guardabassi L, Morley PS, Papich M, Ricciuto DR, Sykes JE. ACVIM consensus statement on therapeutic antimicrobial use in animals and antimicrobial resistance. J Vet Intern Med. 2015;29(2):487-98. doi: 10.1111/jvim.12562.
-
Weese, JS. Scott; Blondeau, Joseph; Boothe, Dawn; Guardabassi, Luca G.; Gumley, Nigel; Papich, Mark et al. (2019): International Society for Companion Animal Infectious Diseases (ISCAID) guidelines for the diagnosis and management of bacterial urinary tract infections in dogs and cats. Vet. J. 2019: 247, S. 8–25. DOI: 10.1016/j.tvjl.2019.02.008.